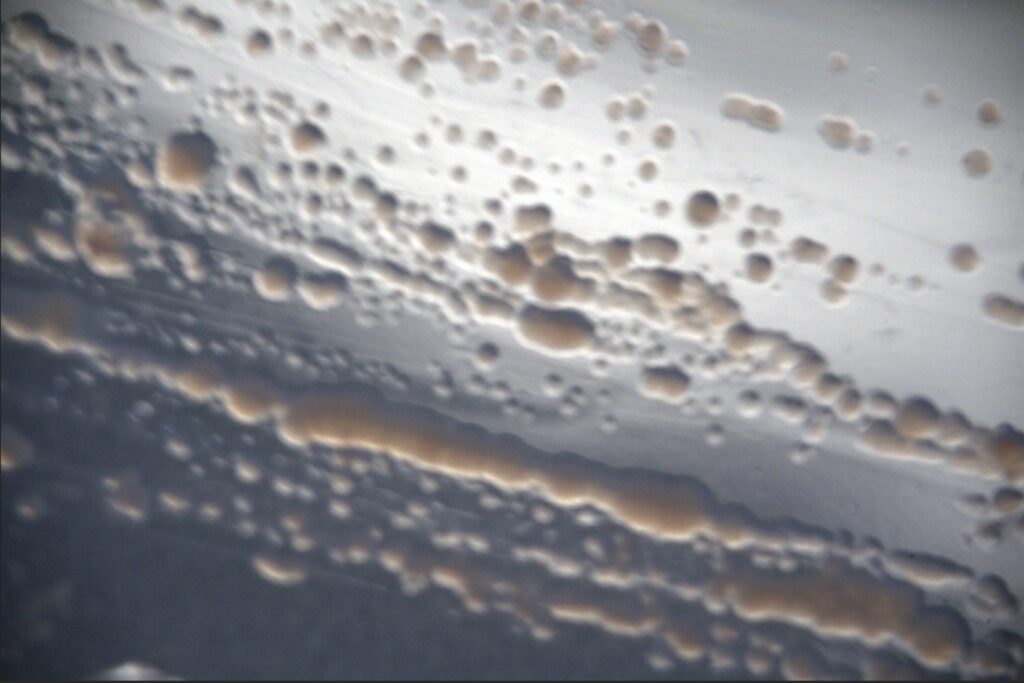
Roseovarius-sp-1024x683 Del desierto de Atacama al espacio: bacterias chilenas podrían revelar vida en otros planetas

Un estudio liderado por científicas del CATA investiga cómo los gases generados por microorganismos extremófilos del norte de Chile podrían convertirse en señales detectables en atmósferas de exoplanetas, abriendo nuevas rutas en la búsqueda de vida fuera de la Tierra.
Los microorganismos que habitan algunos de los ambientes más extremos del planeta podrían entregar pistas clave para la búsqueda de vida fuera del Sistema Solar. Un nuevo estudio realizado en Chile explora cómo los gases producidos por bacterias que viven en salares del desierto de Atacama podrían generar señales detectables en las atmósferas de exoplanetas.
La iniciativa es liderada por Valeska Molina, Investigadora Adscrita del Centro de Astrofísica y Tecnologías Afines – CATA (Centro Basal de ANID) y doctoranda de la Universidad de Atacama (UDA) en colaboración con las científicas Bárbara Rojas-Ayala, Investigadora Asociada del CATA y académica de la Universidad de Tarapacá (UTA) y Cristina Dorador, Investigadora Adscrita del CATA e integrante del Departamento de Biotecnología de la Universidad de Antofagasta (UA).

Valeska Molina, investigadora.
La investigación se centró en la bacteria Roseovarius sp., aislada en el Salar de Llamara en el desierto de Atacama, un ambiente hipersalino del norte de Chile considerado un análogo natural de condiciones que pudieron haber existido en la Tierra primitiva e incluso en otros mundos. A partir del estudio de su metabolismo y de los gases que produce, el equipo analizó si estas moléculas podrían detectarse a escala planetaria mediante observaciones astronómicas.
“Lo más relevante de esta investigación es que conecta directamente el estudio de microorganismos extremófilos del desierto de Atacama con la búsqueda de vida en otros planetas”, explica Valeska Molina, investigadora adscrita del CATA y doctoranda de la Universidad de Atacama, quien lidera el trabajo.
“Analizamos los gases producidos por la bacteria Roseovarius y sus firmas espectrales utilizando espectroscopía Raman e infrarroja, y luego comparamos estas señales con modelos de atmósferas planetarias análogas a la Tierra primitiva”, agrega.
De esta forma, el estudio muestra cómo procesos biológicos microscópicos, como el metabolismo de bacterias extremófilas, podrían generar señales químicas detectables desde enormes distancias. Esto resulta clave para la astrobiología, disciplina que busca identificar posibles biofirmas o indicios de vida en otros planetas.
De los microorganismos a los exoplanetas
La conexión entre microbiología y astronomía se establece a través de los gases que producen los organismos vivos. En la Tierra, muchas moléculas presentes en la atmósfera tienen origen biológico y reflejan procesos metabólicos que ocurren a escala microscópica.
“En la atmósfera actual de la Tierra podemos detectar biofirmas claras, como el oxígeno y el ozono producidos por la fotosíntesis, así como otros gases de origen biológico, como, por ejemplo, metano, óxido nitroso o dimetil sulfuro (fitoplancton marino) que reflejan distintos metabolismos microbianos”, explica Bárbara Rojas-Ayala. “Estos compuestos evidencian cómo la vida puede modificar la composición atmosférica de un planeta”, complementa la investigadora del CATA.
En este estudio, el equipo midió las señales espectrales de gases producidos por la bacteria Roseovarius sp., especialmente monóxido de carbono (CO) y dióxido de carbono (CO₂), para luego compararlas con modelos teóricos de atmósferas planetarias similares a las que pudo tener la Tierra en sus primeras etapas.
Estas simulaciones permiten evaluar si esas moléculas podrían detectarse en observaciones de exoplanetas utilizando telescopios como el James Webb Space Telescope (JWST) o futuros instrumentos de la próxima generación de telescopios extremadamente grandes.
El interés por este tipo de microorganismos se relaciona con la historia temprana de la vida en la Tierra. La bacteria estudiada posee enzimas clave asociadas a metabolismos muy antiguos basados en el carbono, que podrían haber estado presentes en los primeros ecosistemas del planeta.
“Elegimos estudiar Roseovarius sp. porque es una bacteria presente en ambientes extremos como los salares del desierto de Atacama, uno de los lugares más hostiles del planeta. Estos ambientes se consideran análogos naturales de condiciones que podrían existir en otros mundos”, enfatiza Molina.
Según explica Cristina Dorador “esta bacteria realiza fotosíntesis anoxigénica (sin producción de oxígeno) que es anterior a las actuales cianobacterias y era común en tapetes microbianos de la Tierra primitiva”.
Este tipo de metabolismos primitivos resulta especialmente relevante al estudiar exoplanetas, ya que muchos de ellos podrían tener atmósferas muy distintas a la de la Tierra actual.
“Muchos de los exoplanetas potencialmente habitables que conocemos probablemente no se parezcan a la Tierra moderna, por lo que sus biofirmas atmosféricas también podrían ser distintas a las que dominan hoy en nuestro planeta”, señala Rojas-Ayala.
El valor de los ambientes extremos
Los resultados también destacan el valor científico de los ecosistemas extremos del norte de Chile, donde sobreviven microorganismos capaces de adaptarse a condiciones de alta salinidad, radiación y escasez de agua.
Estos ambientes permiten estudiar metabolismos microbianos que podrían ser comunes en otros mundos. “Los extremófilos amplían nuestra comprensión de qué tipos de vida pueden existir y en qué condiciones”, afirma Valeska Molina. “Esto permite refinar, o incluso desafiar, algunas ideas actuales sobre qué señales químicas podrían indicar vida en otros planetas”.
Para Cristina Dorador, además, estos ecosistemas representan un patrimonio natural que debe ser protegido. “Estos ambientes están cada vez más amenazados, por lo que es fundamental avanzar hacia la protección de ambientes análogos a la Tierra primitiva que aún existen”, enfatiza la investigadora.
El equipo planea ampliar este enfoque en futuras investigaciones, incorporando otros microorganismos extremófilos y analizando una mayor diversidad de gases metabólicos que podrían actuar como biofirmas, así como perfeccionar los modelos atmosféricos para considerar distintos tipos de planetas y estrellas.

“Buscaremos mejorar estos modelos incorporando la relación estrella-planeta, ya que no es lo mismo una atmósfera irradiada por una estrella como el Sol que por una enana roja, mucho más pequeña, fría y activa. Ese entorno estelar influye directamente en la química atmosférica, en la acumulación de gases y en la detectabilidad de posibles biofirmas”, explica Bárbara Rojas-Ayala.
“Uno de los objetivos es estimar cuántos tránsitos planetarios serían necesarios para detectar estas biofirmas en las atmósferas de exoplanetas rocosos utilizando instrumentos actuales y futuros. El objetivo final es seguir acercándonos a una pregunta que mueve a toda la astrobiología: ¿cómo reconocer señales de vida cuando observamos otros mundos?”, concluye Valeska Molina.
Compartir este contenido:














Publicar comentario